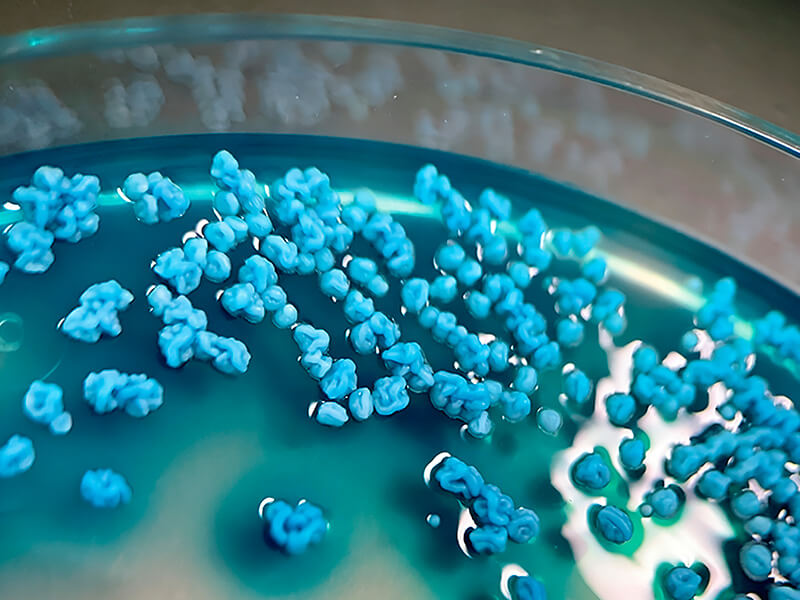
Colonias de Candida allociferrii en CHROMagar Candida Plus
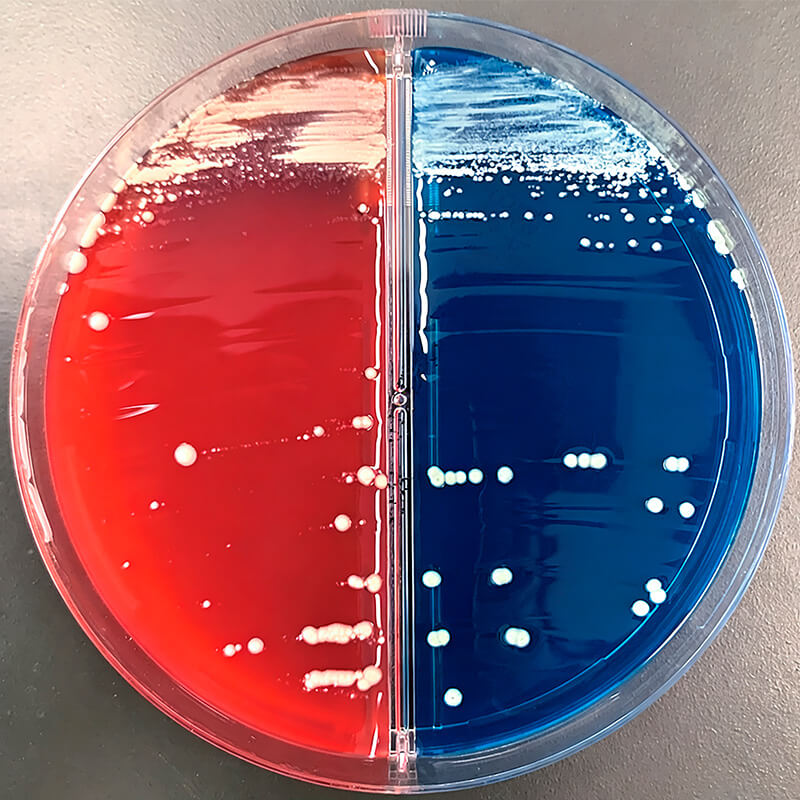
Cultivo TSA/BTB

Candida allociferrii: caso clínico, diagnóstico práctico y claves terapéuticas
Como profesional de laboratorio en un laboratorio clínico, sé que el estudio de las levaduras como agentes etiológicos puede ser un laberinto: medios de cultivo limitados, tecnología que a veces no alcanza para llegar a la especie correcta y cambios taxonómicos que no dan tregua (en Candida, varias especies han migrado a otros géneros). Si no estamos al día, es fácil perderse.
Hace poco leí un artículo en una revista japonesa de tecnología médica sobre una levadura que jamás había escuchado: Candida allociferrii. Esa lectura me empujó a investigar más: qué es, cómo se diagnostica y qué implica para la práctica diaria. Este artículo reúne lo poco que existe publicado y, sobre todo, propone cómo enfrentarse a una Candida poco conocida cuando la tecnología es limitada. Incluso con equipos avanzados como MALDI‑TOF, muchas veces hay que escalar a pruebas moleculares (ITS/D1–D2) para nombrar correctamente a estas especies.
¿Qué es Candida allociferrii? Ubicación dentro del complejo Stephanoascus ciferrii
Candida allociferrii (también reportada dentro del complejo Stephanoascus ciferrii, junto a Candida ciferrii y Candida mucifera) (Fig. 1) es una levadura rara en clínica humana, pero relevante por su potencial de resistencia antifúngica y por presentarse en ciertos sitios anatómicos (p. ej., estructuras oculares y auditivas). En el laboratorio, su identificación puede ser desafiante y no lograr la identificación cuando se apoya exclusivamente en bases de datos incompletas o esquemas presuntivos.
En la práctica como profesionales de laboratorio solemos partir desde la probabilidad: “uno espera las Candida más comunes”. Sin embargo, incluso con equipos avanzados como MALDI-TOF o sistemas automatizados, no siempre se llega al patógeno exacto a la primera. Este tipo de especies “fuera de patrón” justifican mantener un umbral bajo para la confirmación por secuenciación cuando el cuadro clínico o el aspecto de las colonias no calzan con lo habitual.
Para comprender mejor esta levadura, y por qué puede pasar desapercibida, revisemos dos casos clave donde Candida allociferrii fue el agente etiológico y se confirmó con pruebas definitivas. El primero sentó el precedente (2015) y el segundo reafirmá lo complejo de identificar correctamente esta especie.
El primer caso documentado: absceso intraorbitario
En este primer reporte del año 2015, un varón de 79 años en Japón, atendido en el Hospital de la Cruz Roja de Saitama (con apoyo de equipos de Enfermedades Infecciosas y Oftalmología junto a centros universitarios de Tokio), tenía el antecedente de enucleación por melanoma coroideo. Meses después, vuelve a control porque el lado operado empieza a doler, se inflama el párpado y supura. Lo lógico fue pensar en una sobreinfección bacteriana posquirúrgica, pero los antibióticos tópicos (varios esquemas) no cambiaron el curso.
En el laboratorio, el cultivo mostró una levadura que no encajaba con las sospechas habituales y las herramientas de rutina no se ponían de acuerdo. Allí el equipo decidió ir más allá: solicitar pruebas moleculares. El resultado fue tan inesperado como revelador: Candida allociferrii. Con un nuevo desbridamiento y anfotericina B tópica, la lesión cedió en una semana.
¿Qué tuvo de particular?
- Fue el primer caso humano reportado con esta especie.
- La localización intraorbitaria y el contexto posquirúrgico lo hicieron clínicamente desafiante.
- La identificación definitiva requirió secuenciación, cuando la bioquímica y el MALDI no fueron concluyentes.
- El manejo se centró en un abordaje local y dirigido (incluido desbridamiento y terapia tópica), con buena evolución en corto tiempo.
Otomicosis por Candida allociferrii: confirmación por secuenciación
En este segundo caso 10 años después en Chiba, Japón, un hombre en sus 50s llegó con prurito y otorrea derecha. Tras el aseo del oído y el envío de la muestra, el cultivo empezó tímido: microcolonias al primer día. El Gram de colonia mostró una pista poco habitual, levaduras con blastoconidias alineadas en un lado de pseudohifas, y, hacia el día 5, en el CHROMagar Candida Plus las colonias aparecieron arrugadas y como “hundidas” en el medio (Fig. 2).
(Fuente: Koizumi et al., 2025)
Los sistemas de rutina no lograron identificar la especie (incluso con biblioteca actualizada), así que el equipo escaló a secuenciación ITS/D1–D2: el resultado fue Candida allociferrii. Con manejo local (toilette/baño ótico) el paciente mejoró sin antifúngicos, pero el MIC de fluconazol resultó alto, reforzando la necesidad de reportar temprano la sospecha cuando la morfología “no cuadra”.
¿Qué tuvo de particular?
- Escenario ORL frecuente (otomicosis) pero con un agente raro.
- Fenotipo colonial muy distintivo (arrugas + hundimiento) que guio la sospecha.
- MALDI-TOF sin identificación concluyente → secuenciación como decisiva.
- MIC elevado a fluconazol pese a buena evolución clínica con medidas locales.
Diagnóstico de Candida allociferrii en el laboratorio clínico (síntesis de ambos casos)
A partir del absceso intraorbitario (2015) y la otomicosis (2025), se delinean rasgos comunes que orientan el diagnóstico en el laboratorio clínico.

Elementos que se repiten en ambos casos
- Agar cromogénico para Candida: aparición de patrones no clásicos; en el segundo caso, arrugas y hundimiento del medio en CHROMagar Candida Plus (Fig. 2). Estos rasgos funcionan como alertas tempranas.
- Gram de colonia: observación de blastoconidios y pseudohifas; en descripciones del complejo Stephanoascus ciferrii se han visto conidios alineados en un lado de estructuras hifales (Fig. 3), detalle que ayuda a sospechar pero no define.
- Crecimiento en medios convencionales: en agar sangre/BTB el crecimiento es más lento que Candidas habituales; en días sucesivos la colonia puede adoptar relieves particulares, aunque otras especies de Candidas pueden presentar algunas de estas características (Fig. 4).
- Equipamiento automatizado: MALDI‑TOF/VITEK MS y bioquímica (p. ej., API ID32C) pueden fallar o sugerir especies vecinas del complejo cuando las bibliotecas son limitadas. El resultado debe tratarse como tentativo.
- Escalada a pruebas moleculares: la secuenciación (ITS y/o D1–D2) zanja la identificación a nivel de especie cuando hay no‑ID o baja confianza en automatizados.
- Contexto clínico y geográfico: el sitio anatómico (órbita, oído externo) y la procedencia del paciente modulan la sospecha. Ambos casos provienen de Asia; en Latinoamérica puede no haber reportes aún, pero ello no excluye su presencia (viajes, movilidad, subdiagnóstico).
¿Qué hacer en el laboratorio? (Flujo de Trabajo)
Si esta levadura apareciera hoy en nuestro laboratorio, este sería el abordaje pragmático paso a paso:
1. Describir el fenotipo
Observar color en cromogénico, buscar arrugas y hundimiento. Documentar siempre con fotografías para referencia futura.
2. Registrar en el LIS
Ingresar nota interna: “fenotipo no clásico; sospecha Candida atípica o Candida spp. especie por determinar” para alertar al equipo.
3. Correr MALDI‑TOF / Bioquímica
Los sistemas bioquímicos probablemente lo identifiquen como Stephanoascus ciferrii, mientras que MALDI-TOF puede no lograr identificarlo. En tal caso, conviene informar como complejo Stephanoascus ciferrii.
4. Solicitar Secuenciación (ITS/D1–D2)
Con fines epidemiológicos, investigativos o porque el médico así lo solicite, se puede escalar a realizar análisis exacto de especie mediante secuenciación.
5. Integrar Clínica
Analizar sitio de toma, viajes y estado del huésped para dimensionar la relevancia real del hallazgo.
6. Comunicación Laboratorio–Clínica
Imprescindible. Contactar al médico, enviar fotos y acordar reporte tentativo mientras se confirma.
Antifungigrama y resistencias de Candida allociferrii: ¿qué esperar?
Si se mira la película completa de ambos casos, el guion es claro. En el absceso intraorbitario (2015) la levadura no respondió a los azoles (fluconazol e itraconazol) y la recuperación llegó con un abordaje local más anfotericina B tópica, mientras que las equinocandinas mostraron un desempeño in vitro alentador. Años después, en la otomicosis (2025), el antifungigrama volvió a “hablar” en la misma dirección (Tabla 1).
| Antifúngico | MIC (μg/mL) |
|---|---|
| Anfotericina B | 0.5 |
| Flucitosina | 0.5 |
| Fluconazol | 64 |
| Itraconazol | 0.25 |
| Miconazol | 1 |
| Micafungina | 0.06 |
| Voriconazol | 0.5 |
| Caspofungina | 0.25 |
(Fuente: Koizumi et al., 2025)
¿Qué haría un equipo clínico ante la sospecha de C. allociferrii?
En sitios críticos (como órbita o cuadros invasivos), es razonable priorizar anfotericina B (tópica o sistémica según el escenario) o considerar una equinocandina mientras llegan los MICs, evitando anclarse en fluconazol salvo que el perfil lo permita. En compromisos superficiales ORL, muchas veces un manejo local cuidadoso basta; si se necesita antifúngico, un no azólico, por ejemplo, anfotericina B tópica, suele ser la carta prudente. En todos los casos, conviene reportar las MICs y explicitar la tendencia observada (azoles ↑, AMB/equinocandinas ↓) para que el tratante integre la información con la clínica.
Discusión y reflexiones finales sobre Candida allociferrii y las “Candida atípicas”
Hablar de Candida allociferrii es hablar de lo que no esperamos ver y, sin embargo, está ahí. Su identidad dentro del complejo Stephanoascus ciferrii recuerda que la taxonomía de las levaduras evoluciona y que, cuando el laboratorio se apoya solo en perfiles bioquímicos o en librerías incompletas de MALDI, ciertas especies se pierden en el ruido. La primera pista suele ser visual (colonias que no calzan con lo clásico, cromogénicos con colores o relieves “raros”); la confirmación llega, muchas veces, con secuenciación.
Los dos casos que revisamos, órbita (2015) y oído (2025), ponen sobre la mesa tres ideas simples: (1) la posibilidad real de que C. allociferrii sea el agente cuando el sitio anatómico es poco habitual para Candida común; (2) que las herramientas automatizadas pueden fallar y requieren lectura crítica; y (3) que su perfil de susceptibilidad no siempre acompaña a los azoles, en especial fluconazol, mientras que anfotericina B y equinocandinas muestran un desempeño más consistente.
Como profesionales de laboratorio en Latinoamérica, este tipo de casos nos sirve para ensanchar el radar. La baja notificación local no implica ausencia; implica, con frecuencia, subdiagnóstico. Estar preparados es estandarizar algoritmos de escalada (del plato a ITS/D1–D2), documentar fenotipo y comunicar activamente con el clínico. Solo así convertimos un hallazgo “raro” en información accionable que cambia decisiones.
¿Quieres dominar la identificación de levaduras complejas?
No dejes que una especie atípica detenga tu diagnóstico. Profundiza en morfología, pruebas bioquímicas y moleculares con nuestro curso especializado.
Ver Curso: Estudio de LevadurasPuntos clave para llevar al laboratorio
Diagnóstico: Sospecha temprana
- Si el fenotipo en cromogénico y agar sangre no calza con Candida habitual, marcar sospecha de complejo S. ciferrii.
- Tratar MALDI/API como tentativo si la confianza es baja o la especie no está en biblioteca.
- Escalar a ITS/D1–D2 cuando el sitio sea crítico o la terapia dependa de la especie.
Antifungigrama: Resistencias esperadas
- Anticipe MICs elevadas con fluconazol; prudencia con azoles de primera línea.
- Anfotericina B y equinocandinas suelen tener MICs más bajas.
- Al no haber breakpoints, reporte las MICs con contexto clínico.
Checklist rápido
- Fotografía colonias arrugadas en CHROMagar.
- Reporte "sospecha complejo S. ciferrii" si hay no-ID.
- Comunicación directa con el clínico.
Referencias
- Cosio, T., et al. (2024). Stephanoascus ciferrii complex: The current state of infections and drug resistance in humans. Journal of Fungi, 10, 294.
- Koizumi, T., Hayashi, R., Nakajima, N., Kobayashi, S., Yamazaki, M., & Yaguchi, T. (2025). A case of otomycosis caused by Candida allociferrii identified with a molecular identification. Igakukensa / Medical Laboratory Technology, 74(3), 628–633.
- Soki, H., Abo, K., Yamazaki, K., Kojima, T., Oda, T., Uzawa, Y., & Kikuchi, K. (2015). First report of intraorbital abscess caused by Candida allociferrii and specific PCR for differentiating Stephanoascus ciferrii complex species. Medical Mycology Journal, 56(2), E9–E14.
- Ueda‑Nishimura, K., & Mikata, K. (2002). Species distribution of the ascomycetous heterothallic yeast‑like fungus Stephanoascus ciferrii complex: Description of Candida allociferrii sp. nov. and reinstatement of Candida mucifera Kocknová et Sláviková. International Journal of Systematic and Evolutionary Microbiology, 52, 463–471.

